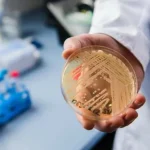
Νοσοκομείο Ρίου: Ο μύκητας candida και οι υγειονομικές προεκτάσεις

Άγριο φονικό στη Φωκίδα – Ομολόγησε ο γιος που βρέθηκε κρυμμένος σε μαντρί
Εντοπίστηκε ζωντανός το μεσημέρι της Τρίτης 26 Σεπτεμβρίου ο 38χρονος, ο οποίος μαζί με τον πατέρα του είχαν εξαφανιστεί στη διαδρομή από τη Λαμία προς την Άρτα. Σε κοντινή απόσταση εντοπίστηκε νεκρός ο 65χρονος πατέρας του. Είχαν εξαφανιστεί με το αυτοκίνητό του, όταν ο πατέρας είχε παραλάβει το γιο του από το νοσοκομείο της Λαμίας.
Σύμφωνα με τις πρώτες πληροφορίες, τον 38χρονο βρήκε κρυμμένο σε ένα μαντρί ένας βοσκός, ο οποίος και κάλεσε την Αστυνομία. Κατά τις ίδιες πληροφορίες ο 38χρονος είπε στους αστυνομικούς ότι σκότωσε τον πατέρα του και υπέδειξε το σημείο όπου βρέθηκε, όπως και το ΙΧ. «Τον χτύπησα με μία πέτρα στο κεφάλι. Εκείνος μου επιτέθηκε πρώτος», φαίνεται να ισχυρίστηκε χαρακτηριστικά.
Ο 38χρονος είναι σε σύγχυση και οι άνδρες της ΕΛ.ΑΣ. προσπαθούν να αντλήσουν πληροφορίες για το τι συνέβη.
Οι έρευνες της αστυνομίας και της ΕΜΑΚ στην ευρύτερη περιοχή της Φωκίδας τις τελευταίες μέρες ήταν εντατικές, καθώς το τελευταίο σήμα του κινητού του 38χρονου. από κεραία κινητής τηλεφωνίας, καταγράφηκε το απόγευμα της Τετάρτης στην ορεινή Ναυπακτία.
Σύμφωνα με πληροφορίες, ο 65χρονος μετέβη στη Λαμία για να παραλάβει τον 38χρονο γιο του, ο οποίος νοσηλεύονταν με ελαφρά τραύματα που είχε υποστεί από τροχαίο ατύχημα στο δρόμο Τυμφρηστού – Καρπενησίου. Επειδή, οι εξετάσεις ήταν καθαρές ο 68χρονος πατέρας πρότεινε στο γιο του να τον μεταφέρει στο σπίτι τους στην Άρτα. Επιβιβάστηκαν στο αυτοκίνητο και μετά από κάποιες ώρες τα ίχνη τους χάθηκαν.
πηγη:zougla.gr